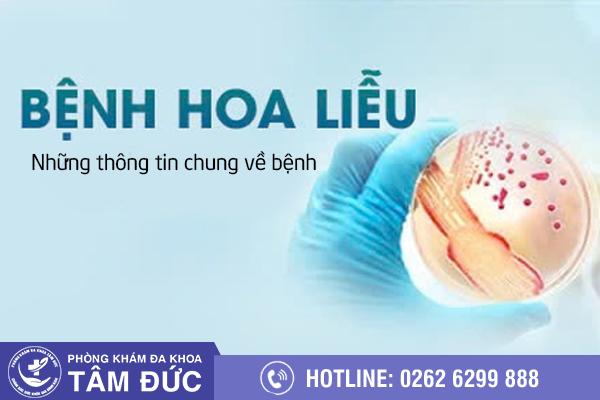

Bệnh hoa liễu có phải là bệnh lây truyền qua đường tình dục không? Hãy cùng Phòng Khám Đa Khoa Tâm Đức tìm hiểu về bệnh hoa liễu ngay bài viết dưới đây. Từ đó người bệnh có được bí quyết để thăm khám và điều trị kịp thời. Tránh để tình trạng bệnh lý ngày càng nặng gây ra nhiều ảnh hưởng đến sức khỏe của người bệnh về sau.
Bệnh hoa liễu là một tên gọi đặc biệt được dùng để chỉ những bệnh xã hội có nguy cơ lây nhiễm cao qua đường quan hệ tình dục. Bao gồm tất cả những hình thức quan hệ tình dục qua đường âm đạo, hậu môn hay cả bằng miệng hoặc thông qua đồ chơi tình dục.
Nguy hiểm hơn, những căn bệnh hoa liễu này không chỉ lây nhiễm qua đường quan hệ tình dục không an toàn. Mà nó còn có thể dễ dàng lây nhiễm qua nhiều con đường khác nhau. Cụ thể như:
+ Lây nhiễm trực truyền từ mẹ truyền sang con
+ Lây nhiễm trực tiếp khi sử dụng chung các vật dụng với người bị nhiễm bệnh.
+ Lây nhiễm trực tiếp và nhanh chóng qua đường máu.
+ Lây qua vết thương hở.
Bệnh hoa liễu ngoài ảnh hưởng tới cuộc sống, sức khỏe và khả năng sinh sản của người bệnh. Mà nó còn ảnh hưởng tới tính mạng của người bệnh, những người không được phát hiện kịp thời ở những giai đoạn đầu thì tỉ lệ tử vong vô cùng cao.
Bạn đang lo lắng khi tiếp xúc với người nhiễm bệnh. Nhấp ngay TẠI ĐÂY để được tư vấn nhanh nhất từ các bác sĩ chuyên khoa nhé.
Mỗi loại bệnh, mỗi loại virus gây bệnh sẽ có thời gian ủ bệnh và phát bệnh nhanh hay chậm rất phức tạp, khó đoán. Có loại bệnh phát triển một cách âm thầm còn có loại thì triển nhanh chóng gây khó khăn cho quá trình kiểm soát và điều trị.

Tính đến thời điểm hiện nay, các chuyên gia sức khỏe đã công bố hiện nay đã xuất hiện rất nhiều loại bệnh hoa liễu với mức độ nguy hiểm khác nhau. Bao gồm các bệnh như: Giang mai, sùi mào gà, bệnh lậu, hạ cam.
+ Sùi mào gà: xuất hiện các triệu chứng như: Nổi mụn thịt, mụn cóc màu trắng hồng ở mắt, miệng, lưỡi, hậu môn, cơ quan sinh dục.
+ Bệnh lậu: Âm đạo hay bao quy đầu tiết nhiều dịch nhầy như mủ, luôn ẩm ướt, ngứa và có mùi hôi khó chịu.
+ Mụn rộp sinh dục: Các mẩn đỏ tại bộ phận sinh dục phát triển thành các mụn nước, mụn mủ mọc riêng lẻ hoặc thành chùm.
+ Giang mai: xuất hiện các vết loét tròn, màu đỏ tươi, không gây ngứa.
Những người có nguy cơ mắc bệnh cao thường có lối sống tình dục không lành mạnh, dính tới các tệ nạn xã hội có thể kể đến. Nếu đang gặp phải các triệu chứng, cần thăm khám và điều trị kịp thời từ các bác sĩ chuyên khoa.
Với sự phát triển vượt bậc của y học hiện nay thì có rất nhiều phương pháp điều trị bệnh hoa liễu. Tuy nhiên, quá trình điều trị còn phụ thuộc nhiều vào tình trạng bệnh, nặng hay nhẹ và tùy vào từng bệnh để có phương pháp điều trị riêng.
⇔ Với những trường hợp bệnh nhẹ, ở những giai đoạn đầu chưa có nhiều nguy hiểm sẽ được điều trị bằng phương pháp nội khoa. Kết hợp với sử dụng thuốc uống và bôi để chữa lành những vết thương loét và ức chế sự phát triển của bệnh.
⇔ Đối với những trường hợp bệnh nặng và ở giai đoạn sau thì các bác sĩ sẽ chỉ định điều trị bằng phương pháp xâm lấn với các kỹ thuật hiện đại như: ALA-PDT cho bệnh sùi mào gà, DHA cho bệnh lậu, GENE cho bệnh giang mai, cân bằng miễn dịch …
Đây được đánh giá là những phương pháp điều trị vô cùng tiên tiến nhiều ưu điểm:
√ Không gây đau đớn,
√ An toàn và mang lại hiệu quả cao,
√ Thời gian điều trị ngắn và hồi phục nhanh.
Chính vì những ưu điểm vượt trội, hầu như có khả năng khắc phục tình trạng bệnh. Do đó mọi người cần tham khảo ý khiến của bác sĩ để được tư vấn phương pháp phù hợp.
Để đặt lịch khám ngoài giờ tại phòng khám, bạn có thể trao đổi với bác sĩ để được tư vấn chi tiết nhất!
Các cách trị bệnh xã hội hiện đại được Phòng Khám Đa Khoa Tâm Đức (Số 07 Đường Bà Triệu, Phường Buôn Ma Thuột, Tỉnh Đắk Lắk) áp dụng, mang lại hiệu quả cao. Phương pháp chữa bệnh xã hội có thể điểm danh như:
• Với sùi mào gà, tùy vào tình trạng sức khỏe của bệnh nhân và giai đoạn bệnh mà có thể áp dụng các phương pháp hỗ trợ điều trị như: Dùng thuốc, đốt laser, ALA-PDT, miễn dịch…
• Với bệnh lậu, tùy vào tình trạng của bệnh mà chuyên gia y tế có thể kết hợp giữa phương pháp nội khoa (dùng thuốc) và phương pháp DHA.
• Với mụn rộp sinh dục, cũng tùy theo tình trạng bệnh của bệnh nhân mà áp dụng riêng lẻ hoặc phối hợp các phương pháp sau: Dùng thuốc, sử dụng vật lý trị liệu, áp dụng liệu pháp miễn dịch gene sinh học INT.
Lưu ý: Để tránh những biến chứng nguy hiểm, người bệnh không nên tự ý mua thuốc về uống, bôi hoặc chữa trị tại cơ sở kém chất lượng.
Nhấp ngay TẠI ĐÂY để được tư vấn về các phương pháp điều trị hiệu quả với các loại bệnh xã hội nhé.
Phòng Khám Đa Khoa Tâm Đức là cơ sở y tế được cấp phép hoạt động trong lĩnh vực khám, xét nghiệm và điều trị bệnh hoa liễu. Tại đây, đảm bảo quy trình an toàn, chuyên nghiệp, hiệu quả, mang đến sự tin tưởng và yên tâm.
++ Chuyên gia tay nghề cao: Phòng khám hội tụ đội ngũ chuyên gia chuyên khoa tay nghề cao. Nhiều năm kinh nghiệm trong điều trị các bệnh lý xã hội.
++ Chất lượng dịch vụ: Phòng khám có hệ thống tư vấn viên chuyên nghiệp, giúp giải đáp mọi thắc mắc cho người bệnh. Trong quá trình điều trị, người bệnh được chăm sóc tận tình, chu đáo cũng như dặn dò những việc cần làm để đảm bảo tốt cho sức khỏe và hồi phục một cách nhanh, hiệu quả.
++ Chi phí điều trị khám hợp lý: Chi phí cho tất cả các hạng mục điều trị đều được niêm yết công khai minh bạch theo quy định của Sở Y Tế.
Phòng Khám Đa Khoa Tâm Đức là một địa chỉ xét nghiệm khám chữa bệnh hoa liễu an toàn, chất lượng mà nhiều người mong muốn tìm kiếm.
Hiện nay, Phòng Khám Đa Khoa Tâm Đức – tại Số 07 Đường Bà Triệu, Phường Buôn Ma Thuột, Tỉnh Đắk Lắk đang xây dựng hệ thống Tư vấn online miễn phí nhanh chóng – đơn giản – thuận tiện, nhằm phục vụ tốt nhất cho nhu cầu khám chữa bệnh với hai kênh tư vấn:
-> Tư vấn qua số điện thoại 0262.6299.888
-> Tư vấn qua chat trực tuyến tại đây
Đừng ngại chia sẻ tình trạng của bạn với các tư vấn chuyên khoa chúng tôi, bởi mọi thắc mắc của bạn sẽ được các tư vấn giải đáp và cho lời khuyên tốt nhất.
Vui lòng để lại số điện thoại, Bác sĩ tư vấn sẽ liên hệ ngay với bạn (Hoàn toàn miễn phí)